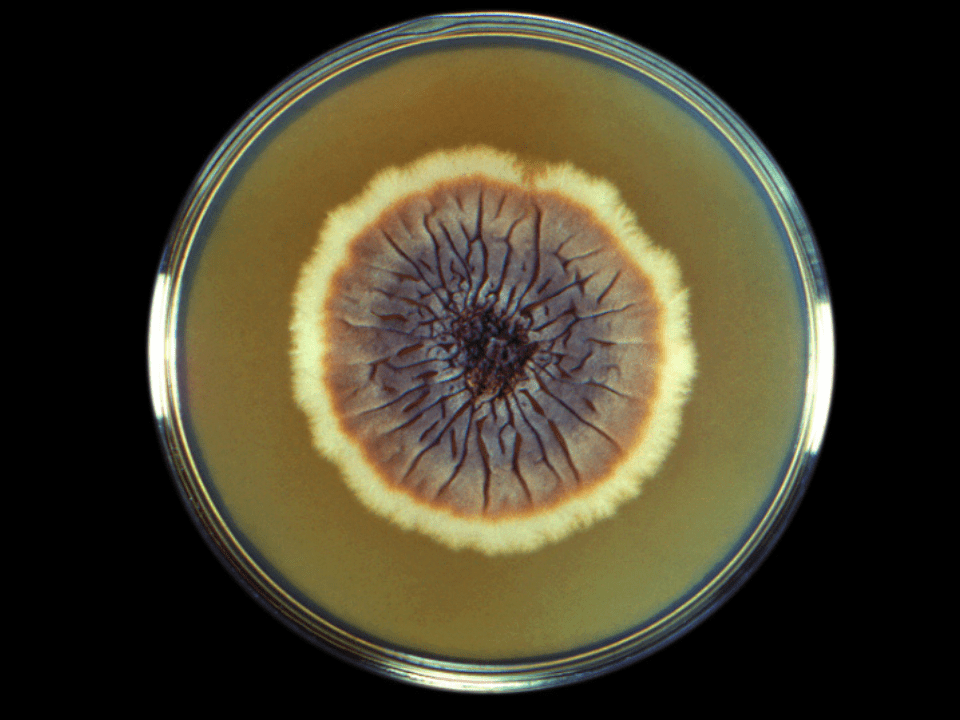
Esporotricose: fungo encontra no Brasil “local perfeito” para epidemia

A esporotricose é a micose subcutânea mais prevalente no mundo, sobretudo em áreas tropicais e subtropicais. A infecção é causada por um fungo e se manifesta por meio de lesões na pele, podendo também causar feridas na mucosa oral e ocular. Sua principal forma de transmissão é por arranhões e mordidas de gatos domésticos infectados, e casos mais graves ocorrem em pacientes imunodeprimidos.
Dos 27 estados do Brasil, 26 apresentam diagnósticos confirmados, e o Rio de Janeiro é considerado o epicentro da doença. Em 2023, 1.239 casos foram registrados no País, e mais 945 casos foram notificados até junho de 2024, caracterizando uma epidemia. Apesar da disponibilidade de tratamento no Sistema Único de Saúde (SUS), a doença ainda não é plenamente identificada: apenas no último dia 30 de janeiro a notificação da esporotricose se tornou obrigatória.
Nesse cenário, pesquisadores da USP publicaram um artigo de perspectiva para chamar a atenção para a reemergência dessa doença. “As doenças fúngicas, de forma silenciosa, vêm se tornando um problema, […] e são subestimadas em relação às doenças bacterianas e virais”, comenta, ao Jornal da USP, Carlos Aguiar, médico veterinário e doutorando no programa de Ciência e Tecnologia de Alimentos da Escola Superior de Agricultura Luiz de Queiroz (Esalq) da USP. Além da ausência de vacinas disponíveis para prevenção, os antifúngicos existentes são extremamente limitados e, no caso da esporotricose, demandam três a seis meses de tratamento.
Aguiar complementa que, nos últimos anos, ocorreu uma grave subnotificação dos casos, o que gera dados não verídicos sobre a gravidade da disseminação no País. “Não sabemos realmente o panorama dessa doença; ela pode estar muito endêmica em uma região ou cidade específica, e isso não é divulgado porque não era notificado pelo sistema de saúde”, critica o cientista. Com a notificação compulsória, todos os casos suspeitos ou confirmados de esporotricose humana devem ser comunicados às autoridades de saúde locais por meio do Sistema de Informação de Agravos de Notificação (Sinan).
O Sporothrix brasiliensis, principal espécie causadora da doença no Brasil, é especialmente adaptado à infecção de mamíferos, pois sobrevive plenamente na temperatura corporal humana (36ºC) e na temperatura corporal felina (cerca de 39ºC). Essa termotolerância favorece o sucesso do fungo em relação a outros membros do gênero Sporothrix, como S. globosa, que não prospera bem acima de 35°C.
Assim, Sporothrix brasiliensis encontrou no País “o local perfeito para uma epidemia desde sua primeira descrição”, também devido à capacidade de infectar hospedeiros de sangue quente e à alta virulência. “Além disso, o grande número de gatos no País, aliado à falta de um sistema de notificação robusto, contribuiu ainda mais para as altas taxas de incidência da doença”, escrevem os pesquisadores.
Formas de transmissão
A esporotricose sapronótica é transmitida por acidentes com espinhos, palha ou lascas de madeira e contato com vegetais em decomposição, habitats naturais do fungo. Isso significa que ele tem capacidade de sobreviver sem um hospedeiro direto, o que amplia a possibilidade de contaminação.
 Em gatos, a micose fere principalmente a face, orelhas e patas, enquanto, em pessoas, a lesão inicial se assemelha a uma picada de inseto — mas, em casos mais graves, pode atingir os pulmões e provocar tosse, falta de ar e febre – Gráfico retirado do artigo
Em gatos, a micose fere principalmente a face, orelhas e patas, enquanto, em pessoas, a lesão inicial se assemelha a uma picada de inseto — mas, em casos mais graves, pode atingir os pulmões e provocar tosse, falta de ar e febre – Gráfico retirado do artigo
Entretanto, sua forma mais comum de transmissão é zoonótica, ou seja, de animais para humanos: gatos que brigam ou se arranham nas ruas com objetos ou outros animais contaminados e, depois, arranham ou mordem seres humanos. “Quando um gato arranha o ser humano, principalmente nos braços, no antebraço e nas pernas, abre uma porta de entrada para o fungo se instalar e gerar essa doença”, explica Aguiar.
O pesquisador reforça que, por esse motivo, é importante manter gatos domésticos dentro de casa. “O gato tem o instinto natural de sair e caçar, mas se sabemos que é um local endêmico dessa doença, devemos evitar que eles tenham contato com outros animais e tragam esse fungo para dentro de casa — e transmitam para humanos”, afirma.
As mudanças climáticas
Para cada 1°C ganho na temperatura corporal entre 30 e 42°C, aproximadamente 6% das espécies de fungos são atualmente excluídas como patógenos potenciais. Nesse sentido, o aquecimento global é particularmente perigoso porque estreita o gradiente térmico entre as condições ambientais e as temperaturas dos mamíferos: com as mudanças climáticas, os fungos tendem a se adaptar a temperaturas mais altas e se tornar mais resistentes, fenômeno que aumenta a morbidade da doença.
O S. brasiliensis cresce no solo e em material vegetal em decomposição, com condições mais quentes e úmidas, criando mais oportunidades para o fungo proliferar e infectar humanos e animais. O pesquisador explica que a ação antrópica sobre o ambiente também é um agravante para a disseminação da esporotricose, visto que o desmatamento e a ocupação de áreas naturais corrobora para que doenças endêmicas se espalhem. “A partir do momento em que a gente desmata esses habitats naturais [do fungo], ele acaba vindo para a área urbana”, comenta.
A reemergência, portanto, é fruto de um conjunto de fatores — mudanças na temperatura e umidade do ar, somadas à urbanização desenfreada, o embate entre o processo de domesticação e o comportamento instintivo dos gatos, e, acima de tudo, uma resposta inadequada do sistema de saúde pública.
Saúde Única
A implantação da vigilância epidemiológica das micoses endêmicas é uma das responsabilidades do Departamento de HIV, Aids, Tuberculose, Hepatites Virais e Infecções Sexualmente Transmissíveis (DATHI), e tem como objetivo ampliar o conhecimento para implantar políticas públicas assertivas de controle e prevenção. Entretanto, para garantir um combate efetivo da doença, Aguiar ressalta a importância da Saúde Única: essa abordagem engloba ações conjuntas entre as diversas esferas da sociedade para promover maior bem-estar humano, animal e ambiental.
Iniciativas em saúde animal incluem a participação de veterinários na prevenção da doença. “Os veterinários que vão tratar diretamente com os animais, que são os principais hospedeiros dessa doença, então é essencial orientar os tutores e fazer o tratamento da forma correta”, explica Aguiar. Essa prática deve ser aliada a políticas em saúde ambiental, como estudos de impacto ambiental mais rigorosos em áreas de preservação e áreas com potencial risco de doenças infecciosas.
O investimento em saúde humana, por sua vez, exige profissionais de saúde focados em diagnósticos mais eficazes e orientados ao paciente para garantir um tratamento adequado. “Campanhas educativas em escolas, universidades e centros servem para informar à população sobre a gravidade da doença, para que as pessoas tenham um olhar mais atento e consigam evitar a propagação”, complementa. Para o pesquisador, a obrigatoriedade da notificação foi um primeiro passo importante em direção à otimização dos diagnósticos e do tratamento.
O artigo Reemergence of zoonotic sporotrichosis in Brazil as a public health threat está disponível on-line e pode ser lido aqui.
Mais informações: carlos.freire@usp.br, com Carlos Aguiar
*Estagiária com orientação de Luiza Caires e Fabiana Mariz
Matéria – Jornal da USP
Imagem – Sporothrix schenckii – Foto: CDC/domínio Público